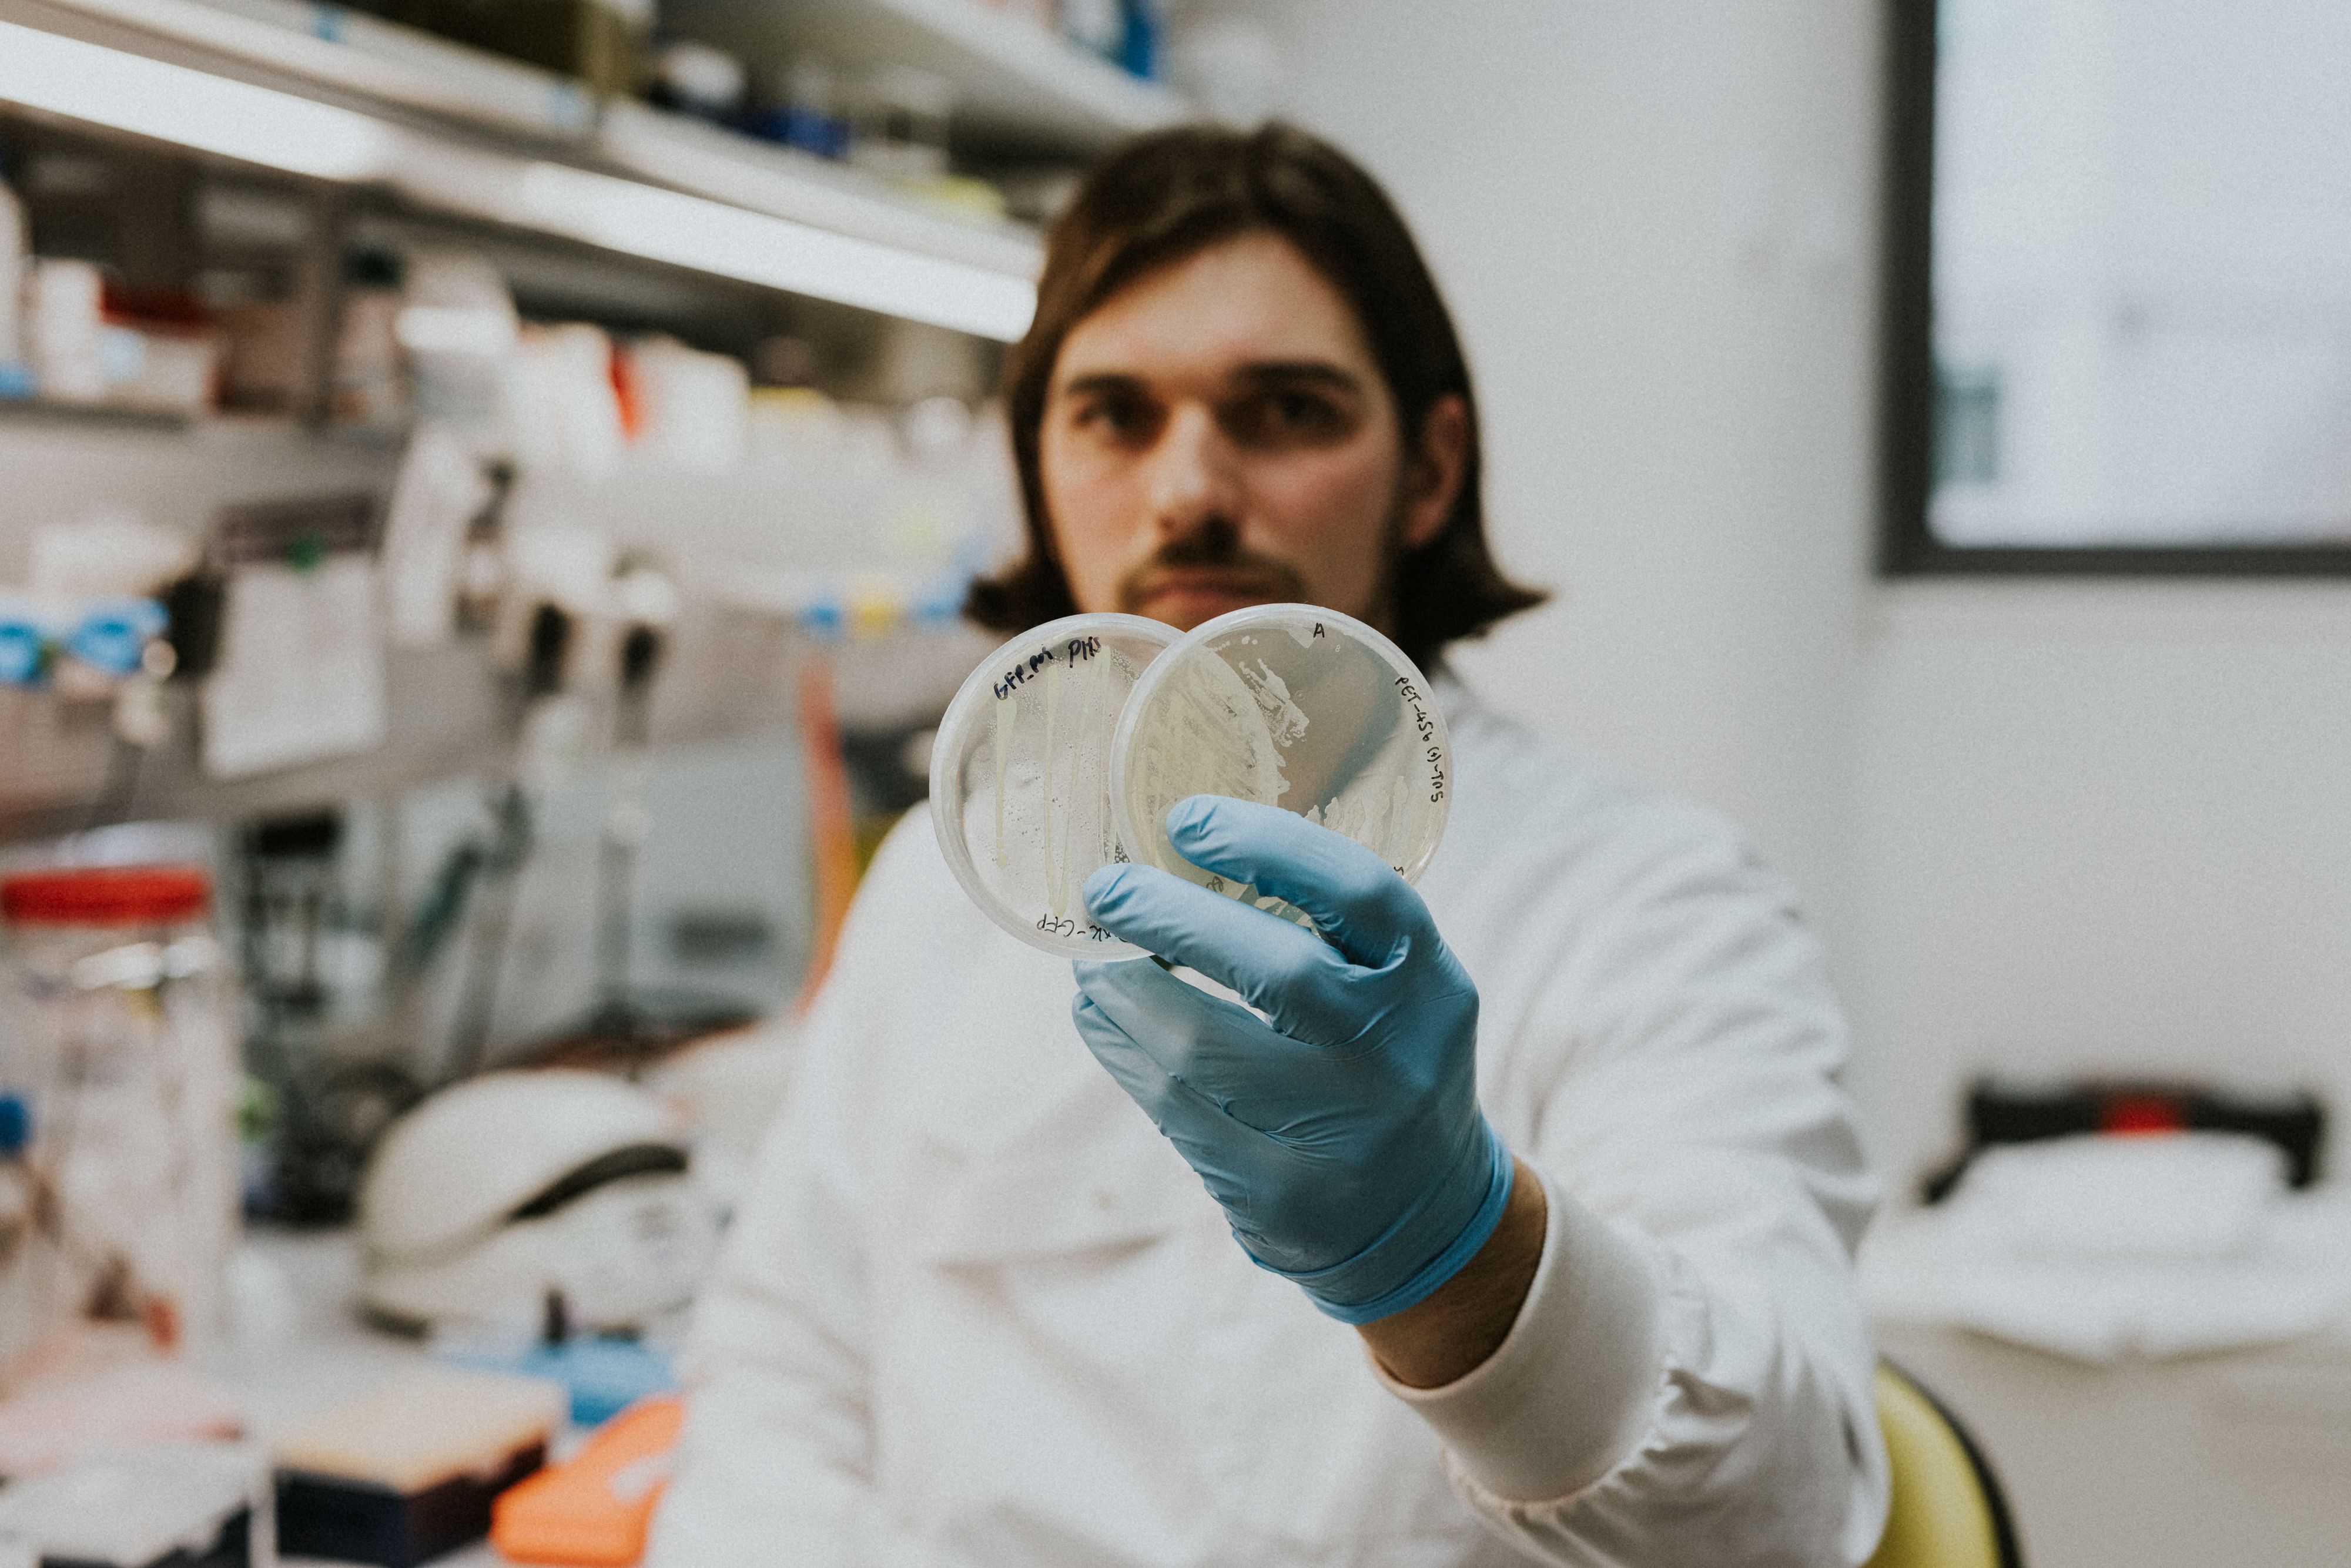
A scientist in a lab coat and blue gloves holding two petri dishes.

Engineering Biology. Accelerated by AI. Powered by Bristol.

The University of Bristol is harnessing engineering biology to address global grand challenges with collaboration, innovation and AI.
With over £150m in funding and more than 17 active engineering biology spinouts, the University of Bristol is at the forefront of turning synthetic biology breakthroughs into businesses that are successfully addressing some of society's most pressing issues. Its secret? A culture of collaboration and connectivity across and beyond its research community.
At its heart, Bristol brings together a powerful and growing community of biochemists, biologists, chemists, engineers, mathematicians, physicists and social scientists to ask: “Can we emulate how biological systems are built and operate?”
Now, home to Isambard AI, the UK’s fastest supercomputer, the University of Bristol is positioned to further advance synthetic biology and the engineering of biological systems.
Can we emulate how biological systems are built and operate?
Engineering biology is a novel, disruptive technology, that is now maturing and becoming an integral part of the world-wide bioeconomy. International think tank Boston Consultancy Group proposes that engineering biology could offer “new ways of producing almost everything that human beings consume, from flavours and fabrics to foods and fuels”.
At a high-level, engineering biology is about designing new biological systems and revolutionising a diverse range of processes from manufacturing through to medicine.
With Isambard AI, discovery is accelerated, test and learn times are reduced and costs of failure minimised. Combined with an ethos of diversity, curiosity and collaboration, the University of Bristol is laying the foundations needed for partnerships to flourish and for businesses to scale sustainably.
From discovery to real-world impact
Engineering biology provides a new lens from which to understand and tackle challenges of the modern world. As the University of Bristol’s discovery-focused engineering biology research portfolio matures, an increasing number of projects are moving toward real-world application.
This includes designing new forms of biosensors and diagnostics, engineering novel functional or sustainable biomaterials, and developing advanced therapeutics, new vaccines, and antimicrobial agents. While diverse, many of these innovations share a common commitment to sustainability and environmental responsibility. As projects move toward use in everyday life, research teams continue to cultivate new cross-sector partnerships to maximise the impact of these innovative technologies.
Science Creates: A prosperous partnership
As a partner of the University, Deep Tech ecosystem Science Creates has played a key role in growing our engineering biology research community into scalable companies, with numerous University spin outs located in its central Bristol incubators.
Utilising knowledge discovery from the University of Bristol, Science Creates has been integral to placing the city firmly on the map as a global centre for the commercialisation of engineering biology. This impact has been delivered through its UK-wide Engineering Biology Accelerator funded by UKRI, its specialised lab space offering and early-stage investment by its venture capital arm, SCVC.
Founded in 2015 by University of Bristol alumnus Harry Destecroix MBE, Science Creates was established due to a lack of commercial lab space in the city. His vision was to create a custom-designed ecosystem, one cultivated by scientists for scientists to facilitate translatable, commercially buoyant research.
This year, Science Creates and the University of Bristol are taking this partnership a step further with the opening of a third Deep Tech incubator in the city, OMX, alongside the University of Bristol's Temple Quarter Enterprise Campus – a new destination for education, innovation, and community collaboration.
More than just a physical space, when it opens in Autumn 2026, Temple Quarter will provide an interdisciplinary environment where start-ups, scale-ups and corporations can access world-class research expertise and entrepreneurial talent from across the University.

Unlocking the power of engineering biology
A number of Bristol-based companies draw on University-generated intellectual property, University-aligned investment, and ongoing links with Bristol’s engineering biology research community. This multidisciplinary portfolio demonstrates the paradigm shifts possible when people collaborate across disciplines and career stages.
This is a culture that comes from the top. University leadership advocates for an open, collaborative and entrepreneurial approach to all research – and works hard to nurture relationships within and beyond Bristol, including with students, the public, industry, government bodies and the arts.
Next on the agenda
With an established reputation as a forerunner in synthetic biology, the University of Bristol is increasing its focus on leveraging the potential of engineering biology to further translate discovery for real-world benefit.
Access to Isambard AI strengthens our position, helping researchers explore ideas more quickly, test more possibilities, and reduce the time and cost associated with early-stage development.
Early-career researchers benefit from bespoke training and mentoring programmes in research, innovation and commercialisation, with funding supporting multiple proof-of-concept projects across a broad array of engineering biology areas.
The integration of AI with Bristol’s growing expertise in the field reflects the University’s ambition to cultivate a distinctive, collaborative research community. Researchers are given the opportunity to work on cutting-edge projects, seize novel opportunities, and shape the future of impactful engineering biology in Bristol and beyond, with AI helping accelerate that journey.

Find out how our research discoveries are unlocking the power of Engineering Biology

Some members of the engineering biology team at University of Bristol
Some members of the engineering biology team at University of Bristol